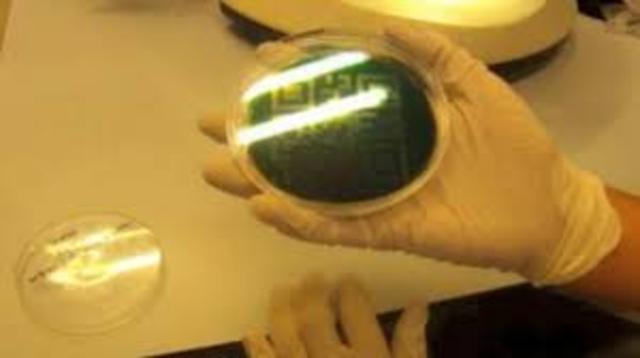
Ciencia y Supervivencia

-
Publicacion de nuestro planata saqueado, es una de las obras pioneras en nuestra materia
-
unos de los tantos eventos que dan la pauta para lo que conosemos como el Derecho Ambiental
-
Se publicó primavera silenciosa. Para analizar las consecuencias de los pesticidas
-
Se publico el libro Ciencia y Supervivencia. esta da vida a movimientos y organizaciones antinuclares
-
Se publicó la bomba de la población. Este era un análisis de los problemas de la explosión demográfica.
-
Los recursos y el hombre. Este informe científico fue para alertar sobre la limitación de los recursos y la explosión demográfica
-
Declaración de Estocolmo. Primera conferencia de naciones unidas sobre el medio ambiente.
-
La central nuclear de whyl. Los activistas antinucleares impidieron la construcción de una central nuclear en Alemania
-
El agujero de la capa de ozono. Científicos británicos anunciaron que observaban un agujero en la capa de ozono sobre la Antártida
-
Comisión mundial sobre el Medio Ambiente y el Desarrollo. Se reúne por primera vez la comisión en la ONU.
-
La NASA y el efecto invernadero, presenta pruebas sobre el Efecto Invernadero
-
La cumbre de la tierra. En rio de Janeiro se efectuó conferencia sobre naciones unidas sobre el medio ambiente y el desarrollo.
A list shows items. A timeline shows sequence.
Use Timetoast to make dates, milestones, and turning points easier to understand in a clear visual format. Timetoast is a timeline maker for work, school, research, and stories.